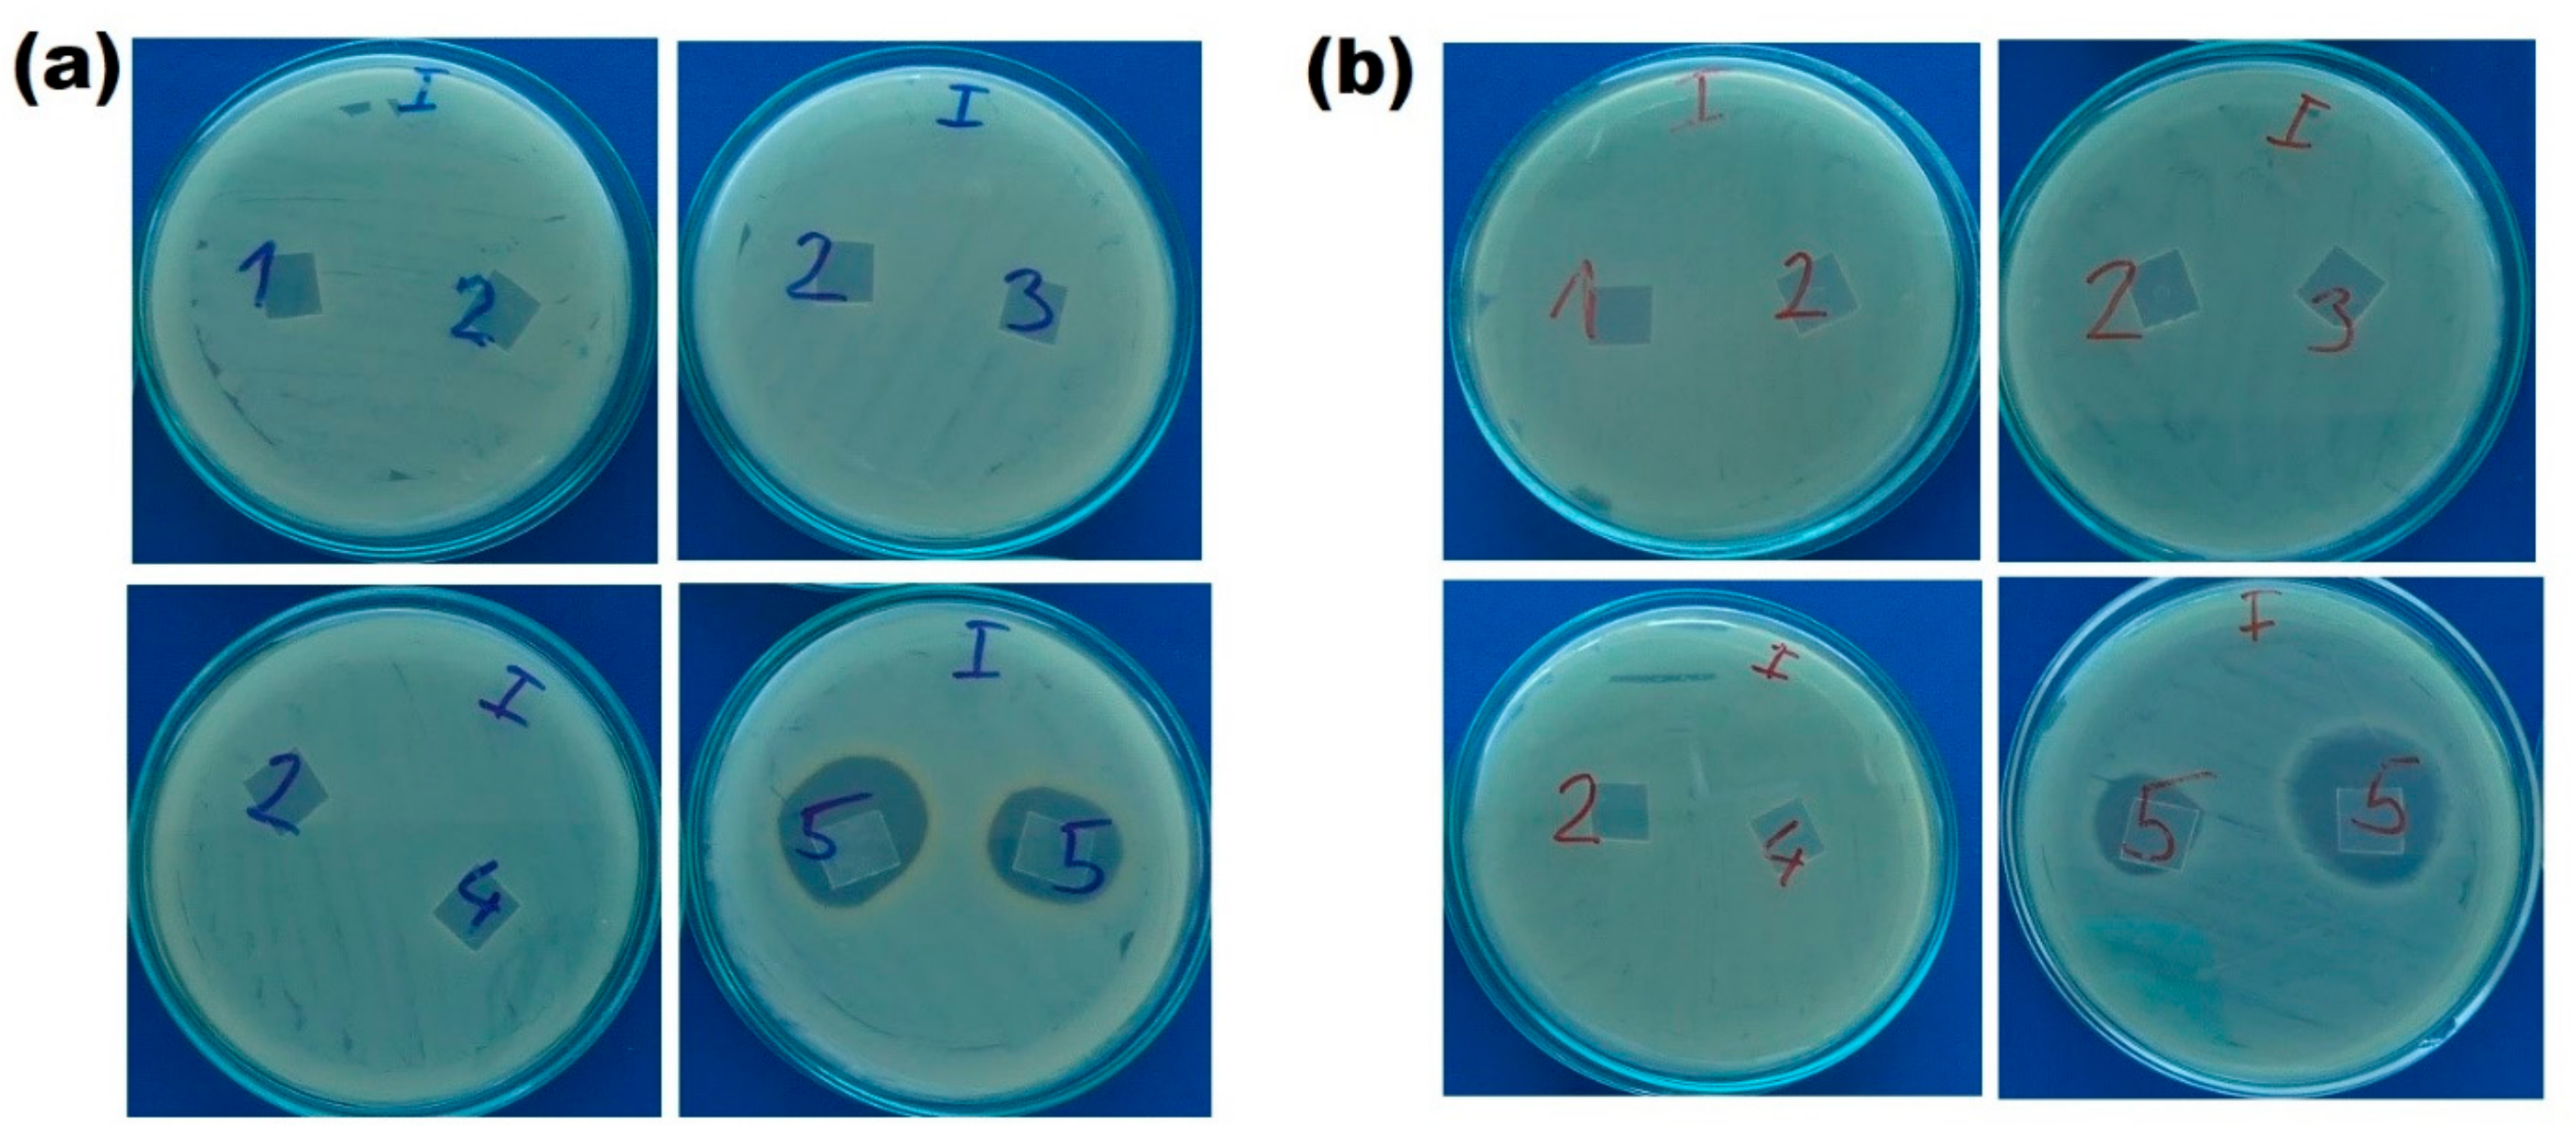
Ijms 23 08821 g008 550

Effect of Saccharides Coating on Antibacterial Potential and Drug Loading and Releasing Capability of Plasma Treated Polylactic Acid Films
Abstract
:1. Introduction
2. Materials and Methods
2.1. Preparation of PLA Films and Surface Functionalization
2.2. Characterizations
2.3. Biocompatibility Testing
2.4. Antibacterial Activity
2.5. Inhibition Zone Assay
2.6. In Vitro Drug Release Studies
3. Results and Discussion
3.1. Surface Morphology and Characterization of PLA Films
3.2. Cytotoxicity of the Films
3.3. Antibacterial Efficiency of PLA Films
3.4. Inhibition Zone Assay
3.5. Drug Release
4. Conclusions
Author Contributions
Funding
Institutional Review Board Statement
Informed Consent Statement
Data Availability Statement
Acknowledgments
Conflicts of Interest
References
- Cloutier, M.; Mantovani, D.; Rosei, F. Antibacterial coatings: Challenges, perspectives, and opportunities. Trends Biotechnol. 2015, 33, 637–652. [Google Scholar] [CrossRef] [PubMed]
- Zhu, X.; Jun Loh, X. Layer-by-layer assemblies for antibacterial applications. Biomater. Sci. 2015, 3, 1505–1518. [Google Scholar] [CrossRef] [PubMed]
- Qin, S.; Xu, K.; Nie, B.; Ji, F.; Zhang, H. Approaches based on passive and active antibacterial coating on titanium to achieve antibacterial activity. J. Biomed. Mater. Res. Part A 2018, 106, 2531–2539. [Google Scholar] [CrossRef]
- Wang, Y.; Yang, Y.; Shi, Y.; Song, H.; Yu, C. Antibiotic-free antibacterial strategies enabled by nanomaterials: Progress and perspectives. Adv. Mater. 2019, 32, 1904106. [Google Scholar] [CrossRef] [PubMed]
- Al-Bayati, F.A. Synergistic antibacterial activity between Thymus vulgaris and Pimpinella anisum essential oils and methanol extracts. J. Ethnopharmacol. 2008, 116, 403–406. [Google Scholar] [CrossRef]
- Hadzhieva, Z.; Boccaccini, A.R. Recent developments in electrophoretic deposition (EPD) of antibacterial coatings for biomedical applications—A Review. Curr. Opin. Biomed. Eng. 2022, 21, 100367. [Google Scholar] [CrossRef]
- Rojas-Martínez, L.E.; Flores-Hernandez, C.G.; López-Marín, L.M.; Martinez-Hernandez, A.L.; Thorat, S.B.; Reyes Vasquez, C.D.; Del Rio-Castillo, A.E.; Velasco-Santos, C. 3D printing of PLA composites scaffolds reinforced with keratin and chitosan: Effect of geometry and structure. Eur. Polym. J. 2020, 141, 110088. [Google Scholar] [CrossRef]
- Ghista, N.D. Poly(Lactic Acid)-Based Biomaterials: Synthesis, Modification and Applications. In Biomedical Science, Engineering and Technology; InTech: London, UK, 2012; pp. 247–250. [Google Scholar]
- Tsou, C.; Yao, W.; Lu, Y.; Tsou, C.; Wu, C.; Chen, J.; Suen, M. Antibacterial property and cytotoxicity of a poly(lactic acid)/nanosilver-doped multiwall carbon nanotube nanocomposite. Polymers 2017, 9, 100. [Google Scholar] [CrossRef] [Green Version]
- Domonkos, M.; Tichá, P.; Trejbal, J.; Demo, P. Applications of cold atmospheric pressure plasma technology in medicine, agriculture and Food Industry. Appl. Sci. 2021, 11, 4809. [Google Scholar] [CrossRef]
- Bekmurzayeva, A.; Duncanson, W.J.; Azevedo, H.S.; Kanayeva, D. Surface modification of stainless steel for biomedical applications: Revisiting a century-old material. Mater. Sci. Eng. C 2018, 93, 1073–1089. [Google Scholar] [CrossRef]
- Amani, H.; Arzaghi, H.; Bayandori, M.; Dezfuli, A.S.; Pazoki-Toroudi, H.; Shafiee, A.; Moradi, L. Controlling cell behavior through the design of biomaterial surfaces: A focus on surface modification techniques. Adv. Mater. Interfaces 2019, 6, 1900572. [Google Scholar] [CrossRef] [Green Version]
- Tendero, C.; Tixier, C.; Tristant, P.; Desmaison, J.; Leprince, P. Atmospheric pressure plasmas: A Review. Spectrochim. Acta Part B At. Spectrosc. 2006, 61, 2–30. [Google Scholar] [CrossRef]
- Barjasteh, A.; Dehghani, Z.; Lamichhane, P.; Kaushik, N.; Choi, E.H.; Kaushik, N.K. Recent progress in applications of non-thermal plasma for water purification, bio-sterilization, and decontamination. Appl. Sci. 2021, 11, 3372. [Google Scholar] [CrossRef]
- Topuzoğullari, M. Effect of polyelectrolyte complex formation on the antibacterial activity of copolymer of alkylated 4-vinylpyridine. Turk. J. Chem. 2020, 44, 634–646. [Google Scholar] [CrossRef] [PubMed]
- Kulkarni, A.D.; Vanjari, Y.H.; Sancheti, K.H.; Patel, H.M.; Belgamwar, V.S.; Surana, S.J.; Pardeshi, C.V. Polyelectrolyte complexes: Mechanisms, critical experimental aspects, and applications. Artif. Cells Nanomed. Biotechnol. 2016, 44, 1615–1625. [Google Scholar] [CrossRef] [PubMed] [Green Version]
- Durmaz, E.N.; Sahin, S.; Virga, E.; de Beer, S.; de Smet, L.C.; de Vos, W.M. Polyelectrolytes as building blocks for next-generation membranes with advanced functionalities. ACS Appl. Polym. Mater. 2021, 3, 4347–4374. [Google Scholar] [CrossRef] [PubMed]
- Ajaya, B. A review on polyelectrolytes (PES) and polyelectrolyte complexes (PECS). Int. J. Eng. Res. 2020, 9, 876–889. [Google Scholar] [CrossRef]
- Thünemann, A.F.; Müller, M.; Dautzenberg, H.; Joanny, J.; Löwen, H. Polyelectrolyte complexes. In Advances in Polymer Science; Springer: Stockholm, Sweden, 2004; pp. 113–171. [Google Scholar]
- Manna, U.; Bharani, S.; Patil, S. Layer-by-layer self-assembly of modified hyaluronic acid/chitosan based on hydrogen bonding. Biomacromolecules 2009, 10, 2632–2639. [Google Scholar] [CrossRef]
- Meka, V.S.; Sing, M.K.G.; Pichika, M.R.; Nali, S.R.; Kolapalli, V.R.M.; Kesharwani, P. A comprehensive review on Polyelectrolyte complexes. Drug Discov. Today 2017, 22, 1697–1706. [Google Scholar] [CrossRef]
- Zilberman, M.; Kraitzer, A.; Grinberg, O.; Elsner, J.J. Drug-Eluting Medical Implants. In Drug Delivery, Handbook of Experimental Pharmacology; Schäfer-Korting, M., Ed.; Springer: Berlin/Heidelberg, Germany, 2010; Volume 197. [Google Scholar]
- Li, Q.; Chen, G.Q.; Liu, L.; Kentish, S.E. Spray assisted layer-by-layer assembled one-bilayer polyelectrolyte reverse osmosis membranes. J. Membr. Sci. 2018, 564, 501–507. [Google Scholar] [CrossRef]
- Safitri, E.; Omaira, Z.; Nazaruddin, N.; Mustafa, I.; Saleha, S.; Idroes, R.; Paristiowati, M. Fabrication of an immobilized polyelectrolite complex (PEC) membrane from pectin-chitosan and chromoionophore ETH 5294 for PH-based fish freshness monitoring. Coatings 2022, 12, 88. [Google Scholar] [CrossRef]
- Su, L.; Feng, Y.; Wei, K.; Xu, X.; Liu, R.; Chen, G. Carbohydrate-based macromolecular biomaterials. Chem. Rev. 2021, 121, 10950–11029. [Google Scholar] [CrossRef] [PubMed]
- Afshar, A.; Gultekinoglu, M.; Edirisinghe, M. Binary polymer systems for biomedical applications. Int. Mater. Rev. 2022, 1–41. [Google Scholar] [CrossRef]
- Li, J.; Zhuang, S. Antibacterial activity of chitosan and its derivatives and their interaction mechanism with bacteria: Current State and Perspectives. Eur. Polym. J. 2020, 138, 109984. [Google Scholar] [CrossRef]
- Wang, M.; Chan, E.W.; Yang, C.; Chen, K.; So, P.-K.; Chen, S. N-acetyl-D-glucosamine acts as adjuvant that re-sensitizes starvation-induced antibiotic-tolerant population of E. coli to β-lactam. IScience 2020, 23, 101740. [Google Scholar] [CrossRef]
- Saxena, S.; Ray, A.R.; Gupta, B. Chitosan immobilization on polyacrylic acid grafted polypropylene monofilament. Carbohydr. Polym. 2010, 82, 1315–1322. [Google Scholar] [CrossRef]
- Pal, D.; Saha, S. Chondroitin: A natural biomarker with immense biomedical applications. RSC Adv. 2019, 9, 28061–28077. [Google Scholar] [CrossRef] [Green Version]
- Sharma, S.; Swetha, K.L.; Roy, A. Chitosan-chondroitin sulfate based polyelectrolyte complex for effective management of chronic wounds. Int. J. Biol. Macromol. 2019, 132, 97–108. [Google Scholar] [CrossRef]
- Sharma, R.; Kuche, K.; Thakor, P.; Bhavana, V.; Srivastava, S.; Mehra, N.K.; Jain, S. Chondroitin sulfate: Emerging biomaterial for biopharmaceutical purpose and tissue engineering. Carbohydr. Polym. 2022, 286, 119305. [Google Scholar] [CrossRef]
- Sivakumar, P.M.; Yetisgin, A.A.; Sahin, S.B.; Demir, E.; Cetinel, S. Bone Tissue Engineering: Anionic polysaccharides as promising scaffolds. Carbohydr. Polym. 2022, 283, 119142. [Google Scholar] [CrossRef]
- Karakurt, I.; Ozaltin, K.; Vesela, D.; Lehocky, M.; Humpolíček, P.; Mozetič, M. Antibacterial activity and cytotoxicity of immobilized glucosamine/chondroitin sulfate on polylactic acid films. Polymers 2019, 11, 1186. [Google Scholar] [CrossRef] [PubMed] [Green Version]
- Elwenspoek, M.; Jansen, H.V. What is plasma etching? In Silicon Micromachining; Cambridge University Press: Cambridge, UK, 2004; pp. 206–268. [Google Scholar]
- Choi, H.-S.; Kim, Y.-S.; Zhang, Y.; Tang, S.; Myung, S.-W.; Shin, B.-C. Plasma-induced graft co-polymerization of acrylic acid onto the polyurethane surface. Surf. Coat. Technol. 2004, 182, 55–64. [Google Scholar] [CrossRef]
- Liu, P. Modification of polymeric materials via surface-initiated controlled/“living” radical polymerization. e-Polymers 2007, 7, 725–755. [Google Scholar] [CrossRef]
- Friedrich, J. Mechanisms of plasma polymerization—Reviewed from a chemical point of view. Plasma Processes Polym. 2011, 8, 783–802. [Google Scholar] [CrossRef]
- Pâslaru, E.; Fras Zemljic, L.; Bračič, M.; Vesel, A.; Petrinić, I.; Vasile, C. Stability of a chitosan layer deposited onto a polyethylene surface. J. Appl. Polym. Sci. 2013, 130, 2444–2457. [Google Scholar] [CrossRef]
- Gohil, S.V.; Padmanabhan, A.; Deschamps, J.; Nair, L.S. Chitosan-based scaffolds for growth factor delivery. In Chitosan Based Biomaterials Volume 2; Woodhead Publishing: Sawston, UK, 2017; pp. 175–207. [Google Scholar] [CrossRef]
- Sarrigiannidis, S.O.; Rey, J.M.; Dobre, O.; González-García, C.; Dalby, M.J.; Salmeron-Sanchez, M. A tough act to follow: Collagen hydrogel modifications to improve mechanical and growth factor loading capabilities. Mater. Today Bio 2021, 10, 100098. [Google Scholar] [CrossRef] [PubMed]
- Elzahhar, P.; Belal, A.S.; Elamrawy, F.; Helal, N.A.; Nounou, M.I. Bioconjugation in drug delivery: Practical perspectives and future perceptions. Pharm. Nanotechnol. 2019, 2000, 125–182. [Google Scholar] [CrossRef]
- Abusrafa, E.A.; Habib, S.; Krupa, I.; Ouederni, M.; Popelka, A. Modification of polyethylene by RF plasma in different/mixture gases. Coatings 2019, 9, 145. [Google Scholar] [CrossRef] [Green Version]
- Bahrami, N.; Nouri Khorasani, S.; Mahdavi, H.; Ghiaci, M.; Mokhtari, R. Low-pressure plasma surface modification of polyurethane films with chitosan and collagen biomolecules. J. Appl. Polym. Sci. 2019, 136, 47567. [Google Scholar] [CrossRef]
- Cui, M.; Ng, W.S.; Wang, X.; Darmawan, P.; Lee, P.S. Enhanced electrochromism with rapid growth layer-by-layer assembly of Polyelectrolyte complexes. Adv. Funct. Mater. 2014, 25, 401–408. [Google Scholar] [CrossRef]
- Boddohi, S.; Moore, N.; Johnson, P.A.; Kipper, M.J. Polysaccharide-based polyelectrolyte complex nanoparticles from chitosan, heparin, and hyaluronan. Biomacromolecules 2009, 10, 1402–1409. [Google Scholar] [CrossRef] [PubMed]
- Qu, Z.; Chen, K.; Gu, H.; Xu, H. Covalent immobilization of proteins on 3D poly(acrylic acid) brushes: Mechanism study and a more effective and controllable process. Bioconjug. Chem. 2014, 25, 370–378. [Google Scholar] [CrossRef] [PubMed]
- Rocca-Smith, J.R.; Karbowiak, T.; Marcuzzo, E.; Sensidoni, A.; Piasente, F.; Champion, D.; Heinz, O.; Vitry, P.; Bourillot, E.; Lesniewska, E.; et al. Impact of Corona treatment on PLA Film Properties. Polym. Degrad. Stab. 2016, 132, 109–116. [Google Scholar] [CrossRef]
- De Geyter, N.; Morent, R.; Desmet, T.; Trentesaux, M.; Gengembre, L.; Dubruel, P.; Leys, C.; Payen, E. Plasma modification of polylactic acid in a medium pressure DBD. Surf. Coat. Technol. 2010, 204, 3272–3279. [Google Scholar] [CrossRef]
- Zimina, A.; Senatov, F.; Choudhary, R.; Kolesnikov, E.; Anisimova, N.; Kiselevskiy, M.; Orlova, P.; Strukova, N.; Generalova, M.; Manskikh, V.; et al. Biocompatibility and physico-chemical properties of highly porous PLA/ha scaffolds for bone reconstruction. Polymers 2020, 12, 2938. [Google Scholar] [CrossRef]
- Almodóvar, J.; Place, L.W.; Gogolski, J.; Erickson, K.; Kipper, M.J. Layer-by-layer assembly of polysaccharide-based Polyelectrolyte multilayers: A spectroscopic study of hydrophilicity, composition, and ion pairing. Biomacromolecules 2011, 12, 2755–2765. [Google Scholar] [CrossRef]
- Demina, T.S.; Piskarev, M.S.; Romanova, O.A.; Gatin, A.K.; Senatulin, B.R.; Skryleva, E.A.; Zharikova, T.M.; Gilman, A.B.; Kuznetsov, A.A.; Akopova, T.A.; et al. Plasma treatment of poly(ethylene terephthalate) films and chitosan deposition: DC- vs. AC-Discharge. Materials 2020, 13, 508. [Google Scholar] [CrossRef] [Green Version]
- Ding, Z.; Chen, J.; Gao, S.; Chang, J.; Zhang, J.; Kang, E.T. Immobilization of chitosan onto poly-L-lactic acid film surface by plasma graft polymerization to control the morphology of fibroblast and liver cells. Biomaterials 2004, 25, 1059–1067. [Google Scholar] [CrossRef]
- Hwang, Y.J.; Qiu, Y.; Zhang, C.; Jarrard, B.; Stedeford, R.; Tsai, J.; Park, Y.C.; McCord, M. Effects of atmospheric pressure helium/air plasma treatment on adhesion and mechanical properties of aramid fibers. J. Adhes. Sci. Technol. 2003, 17, 847–860. [Google Scholar] [CrossRef]
- Chauvin, J.; Judée, F.; Yousfi, M.; Vicendo, P.; Merbahi, N. Analysis of reactive oxygen and nitrogen species generated in three liquid media by low temperature helium plasma jet. Sci. Rep. 2017, 7, 4562. [Google Scholar] [CrossRef]
- Donegan, M.; Milosavljević, V.; Dowling, D.P. Activation of pet using an RF atmospheric plasma system. Plasma Chem. Plasma Process. 2013, 33, 941–957. [Google Scholar] [CrossRef]
- Recek, N.; Jaganjac, M.; Kolar, M.; Milkovic, L.; Mozetič, M.; Stana-Kleinschek, K.; Vesel, A. Protein adsorption on various plasma-treated polyethylene terephthalate substrates. Molecules 2013, 18, 12441–12463. [Google Scholar] [CrossRef] [PubMed]
- Liu, S.; Qin, S.; He, M.; Zhou, D.; Qin, Q.; Wang, H. Current applications of poly(lactic acid) composites in tissue engineering and drug delivery. Compos. Part B Eng. 2020, 199, 108238. [Google Scholar] [CrossRef]
- Khorasani, M.T.; MoemenBellah, S.; Mirzadeh, H.; Sadatnia, B. Effect of surface charge and hydrophobicity of polyurethanes and silicone rubbers on L929 cells response. Colloids Surf. B Biointerfaces 2006, 51, 112–119. [Google Scholar] [CrossRef] [PubMed]
- Chang, E. Low proliferation and high apoptosis of osteoblastic cells on hydrophobic surface are associated with defective Ras Signaling. Exp. Cell Res. 2004, 303, 197–206. [Google Scholar] [CrossRef]
- Pearce, A.; O’Reilly, R. Polymers for biomedical applications: The importance of hydrophobicity in directing biological interactions and application efficacy. Biomacromolecules 2021, 22, 4459–4469. [Google Scholar] [CrossRef]
- Roach, P.; Farrar, D.; Perry, C.C. Interpretation of protein adsorption: Surface-induced conformational changes. J. Am. Chem. Soc. 2005, 127, 8168–8173. [Google Scholar] [CrossRef]
- Visalakshan, R.M.; MacGregor, M.N.; Sasidharan, S.; Ghazaryan, A.; Mierczynska-Vasilev, A.M.; Morsbach, S.; Mailänder, V.; Landfester, K.; Hayball, J.D.; Vasilev, K. Biomaterial surface hydrophobicity-mediated serum protein adsorption and immune responses. ACS Appl. Mater. Interfaces 2019, 11, 27615–27623. [Google Scholar] [CrossRef]
- Mitra, S.P. Protein Adsorption on Biomaterial Surfaces: Subsequent Conformational and Biological Consequences. Inform. J. 2020, 36, 7–38. [Google Scholar] [CrossRef]
- Barberi, J.; Spriano, S. Titanium and protein adsorption: An overview of mechanisms and effects of surface features. Materials 2021, 14, 1590. [Google Scholar] [CrossRef]
- Kubiak-Ossowska, K.; Jachimska, B.; Al Qaraghuli, M.; Mulheran, P.A. Protein interactions with negatively charged inorganic surfaces. Curr. Opin. Colloid Interface Sci. 2019, 41, 104–117. [Google Scholar] [CrossRef] [Green Version]
- Li, C.; Guo, C.; Fitzpatrick, V.; Ibrahim, A.; Zwierstra, M.J.; Hanna, P.; Lechtig, A.; Nazarian, A.; Lin, S.J.; Kaplan, D.L. Design of biodegradable, implantable devices towards clinical translation. Nat. Rev. Mater. 2019, 5, 61–81. [Google Scholar] [CrossRef]
- Gaharwar, A.K.; Singh, I.; Khademhosseini, A. Engineered biomaterials for in situ tissue regeneration. Nat. Rev. Mater. 2020, 5, 686–705. [Google Scholar] [CrossRef]
- Skopinska-Wisniewska, J.; Tuszynska, M.; Olewnik-Kruszkowska, E. Comparative study of gelatin hydrogels modified by various cross-linking agents. Materials 2021, 14, 396. [Google Scholar] [CrossRef] [PubMed]
- Kazemi, M.S.; Mohammadi, Z.; Amini, M.; Yousefi, M.; Tarighi, P.; Eftekhari, S.; Rafiee Tehrani, M. Thiolated Chitosan-Lauric acid as a new chitosan derivative: Synthesis, characterization and cytotoxicity. Int. J. Biol. Macromol. 2019, 136, 823–830. [Google Scholar] [CrossRef]
- Rahmani, S.; Mohammadi, Z.; Amini, M.; Isaei, E.; Taheritarigh, S.; Rafiee Tehrani, N.; Rafiee Tehrani, M. Methylated 4-N,N dimethyl aminobenzyl N,O carboxymethyl chitosan as a new chitosan derivative: Synthesis, characterization, cytotoxicity and antibacterial activity. Carbohydr. Polym. 2016, 149, 131–139. [Google Scholar] [CrossRef]
- Keleştemur, S.; Altunbek, M.; Culha, M. Influence of EDC/NHS coupling chemistry on stability and cytotoxicity of zno nanoparticles modified with proteins. Appl. Surf. Sci. 2017, 403, 455–463. [Google Scholar] [CrossRef]
- Mäkilä, E.; Bimbo, L.M.; Kaasalainen, M.; Herranz, B.; Airaksinen, A.J.; Heinonen, M.; Kukk, E.; Hirvonen, J.; Santos, H.A.; Salonen, J. Amine modification of thermally carbonized porous silicon with silane coupling chemistry. Langmuir 2012, 28, 14045–14054. [Google Scholar] [CrossRef]
- Lee, J.H.; Lim, Y.-B.; Choi, J.S.; Lee, Y.; Kim, T.-I.; Kim, H.J.; Yoon, J.K.; Kim, K.; Park, J.-S. Polyplexes assembled with internally quaternized pamam-oh Dendrimer and plasmid DNA have a neutral surface and gene delivery potency. Bioconjug. Chem. 2003, 14, 1214–1221. [Google Scholar] [CrossRef]
- Castel-Molieres, M.; Conzatti, G.; Torrisani, J.; Rouilly, A.; Cavalie, S.; Carrere, N.; Tourrette, A. Influence of homogenization technique and blend ratio on chitosan/alginate polyelectrolyte complex properties. J. Med. Biol. Eng. 2017, 38, 10–21. [Google Scholar] [CrossRef] [Green Version]
- Hampitak, P.; Melendrez, D.; Iliut, M.; Fresquet, M.; Parsons, N.; Spencer, B.; Jowitt, T.A.; Vijayaraghavan, A. Protein interactions and conformations on graphene-based materials mapped using a quartz-crystal microbalance with dissipation monitoring (QCM-D). Carbon 2020, 165, 317–327. [Google Scholar] [CrossRef]
- Tzankova, V.; Aluani, D.; Yordanov, Y.; Valoti, M.; Frosini, M.; Spassova, I.; Kovacheva, D.; Tzankov, B. In vitro toxicity evaluation of lomefloxacin-loaded MCM-41 mesoporous silica nanoparticles. Drug Chem. Toxicol. 2019, 44, 238–249. [Google Scholar] [CrossRef] [PubMed]
- Pessina, A.; Gribaldo, L.; Mineo, E.; Neri, M.G. In vitro short-term and long-term cytotoxicity of fluoroquinolones on murine cell lines. Indian J. Exp. Biol. 1994, 32, 113–118. [Google Scholar] [PubMed]
- Harry, J. Plasma an Overview/Elastic and Inelastic Collision Processes in Weakly Ionized Gases. In Introduction to Plasma Technology Science, Engineering and Applications; Wiley-VCH: Weinheim, Germany, 2010; pp. 1–29. [Google Scholar]
- Im, A.-R.; Kim, J.Y.; Kim, H.-S.; Cho, S.; Park, Y.; Kim, Y.S. Wound healing and antibacterial activities of chondroitin sulfate- and acharan sulfate-reduced silver nanoparticles. Nanotechnology 2013, 24, 395102. [Google Scholar] [CrossRef] [PubMed]
- Benhabiles, M.; Salah, R.; Lounici, H.; Drouiche, N.; Goosen, M.; Mameri, N. Antibacterial activity of chitin, chitosan and its oligomers prepared from shrimp shell waste. Food Hydrocoll. 2012, 29, 48–56. [Google Scholar] [CrossRef]
- Palanisamy, S.; Vinosha, M.; Rajasekar, P.; Anjali, R.; Sathiyaraj, G.; Marudhupandi, T.; Selvam, S.; Prabhu, N.M.; You, S.G. Antibacterial efficacy of a fucoidan fraction (FU-F2) extracted from Sargassum polycystum. Int. J. Biol. Macromol. 2019, 125, 485–495. [Google Scholar] [CrossRef]
- Krichen, F.; Karoud, W.; Sila, A.; Abdelmalek, B.E.; Ghorbel, R.; Ellouz-Chaabouni, S.; Bougatef, A. Extraction, characterization and antimicrobial activity of sulfated polysaccharides from Fish Skins. Int. J. Biol. Macromol. 2015, 75, 283–289. [Google Scholar] [CrossRef]
- Abdelhedi, O.; Nasri, R.; Souissi, N.; Nasri, M.; Jridi, M. Sulfated polysaccharides from common Smooth hound: Extraction and assessment of anti-ACE, antioxidant and antibacterial activities. Carbohydr. Polym. 2016, 152, 605–614. [Google Scholar] [CrossRef]
- No, H. Antibacterial activity of chitosans and chitosan oligomers with different molecular weights. Int. J. Food Microbiol. 2002, 74, 65–72. [Google Scholar] [CrossRef]
- Zheng, L.-Y.; Zhu, J.-F. Study on antimicrobial activity of chitosan with different molecular weights. Carbohydr. Polym. 2003, 54, 527–530. [Google Scholar] [CrossRef]
- Bretado-Aragón, L.A.; Jiménez-Mejía, R.; López-Meza, J.E.; Loeza-Lara, P.D. Composites of silver-chitosan nanoparticles a potential source for new antimicrobial therapies. Rev. Mex. Cienc. Farm. 2018, 47, 7–25. [Google Scholar]
- Liu, M.; Liu, Y.; Cao, M.-J.; Liu, G.-M.; Chen, Q.; Sun, L.; Chen, H. Antibacterial activity and mechanisms of depolymerized fucoidans isolated from Laminaria japonica. Carbohydr. Polym. 2017, 172, 294–305. [Google Scholar] [CrossRef] [PubMed]
- Muanprasat, C.; Chatsudthipong, V. Chitosan oligosaccharide: Biological activities and potential therapeutic applications. Pharmacol. Ther. 2017, 170, 80–97. [Google Scholar] [CrossRef] [PubMed]
- Dalirfardouei, R.; Karimi, G.; Jamialahmadi, K. Molecular mechanisms and biomedical applications of glucosamine as a potential multifunctional therapeutic agent. Life Sci. 2016, 152, 21–29. [Google Scholar] [CrossRef] [PubMed]
- Gómez, M.A.; Bonilla, J.M.; Coronel, M.A.; Martínez, J.; Morán-Trujillo, L.; Orellana, S.L.; Vidal, A.; Giacaman, A.; Morales, C.; Torres-Gallegos, C.; et al. Antibacterial activity against Staphylococcus aureus of chitosan/chondroitin sulfate nanocomplex aerogels alone and enriched with erythromycin and elephant garlic (Allium ampeloprasum L. var. Ampeloprasum) extract. Pure Appl. Chem. 2018, 90, 885–900. [Google Scholar] [CrossRef]
- Shelke, N.B.; James, R.; Laurencin, C.T.; Kumbar, S.G. Polysaccharide biomaterials for drug delivery and Regenerative Engineering. Polym. Adv. Technol. 2014, 25, 448–460. [Google Scholar] [CrossRef]
- Abdullah, T.A.; Ibrahim, N.J.; Warsi, M.H. Chondroitin sulfate-chitosan nanoparticles for ocular delivery of bromfenac sodium: Improved permeation, retention, and penetration. Int. J. Pharm. Investig. 2016, 6, 96. [Google Scholar] [CrossRef] [PubMed] [Green Version]

| Sample Type | Contact Angle (%) |
|---|---|
| PLA | 81.5 ± 1.4 |
| RF | 46.1 ± 0.8 |
| CS | 62.6 ± 1.2 |
| g-CS | 69.4 ± 1.6 |
| g-CS-ChS | 50.9 ± 0.9 |
| Sample Type | Composition (%) | Ratio | ||||
|---|---|---|---|---|---|---|
| C | O | N | F | S | N/C | |
| PLA | 70.9 | 28.4 | - | - | - | - |
| RF | 65.3 | 31.9 | 2.7 | - | - | 0.041 |
| CS | 77.6 | 19.4 | 3.0 | - | - | 0.044 |
| g-CS | 74.1 | 22.2 | 3.6 | - | - | 0.048 |
| g-CS-ChS | 60.9 | 26.6 | 10.1 | - | 0.5 | 0.165 |
| g-CS-ChS-L | 64.6 | 27.8 | 6.9 | 0.6 | 0.4 | 0.107 |
Publisher’s Note: MDPI stays neutral with regard to jurisdictional claims in published maps and institutional affiliations. |
© 2022 by the authors. Licensee MDPI, Basel, Switzerland. This article is an open access article distributed under the terms and conditions of the Creative Commons Attribution (CC BY) license (https://creativecommons.org/licenses/by/4.0/).
Share and Cite
Karakurt, I.; Ozaltin, K.; Pištěková, H.; Vesela, D.; Michael-Lindhard, J.; Humpolícek, P.; Mozetič, M.; Lehocky, M. Effect of Saccharides Coating on Antibacterial Potential and Drug Loading and Releasing Capability of Plasma Treated Polylactic Acid Films. Int. J. Mol. Sci. 2022, 23, 8821. https://doi.org/10.3390/ijms23158821
Karakurt I, Ozaltin K, Pištěková H, Vesela D, Michael-Lindhard J, Humpolícek P, Mozetič M, Lehocky M. Effect of Saccharides Coating on Antibacterial Potential and Drug Loading and Releasing Capability of Plasma Treated Polylactic Acid Films. International Journal of Molecular Sciences. 2022; 23(15):8821. https://doi.org/10.3390/ijms23158821
Chicago/Turabian StyleKarakurt, Ilkay, Kadir Ozaltin, Hana Pištěková, Daniela Vesela, Jonas Michael-Lindhard, Petr Humpolícek, Miran Mozetič, and Marian Lehocky. 2022. "Effect of Saccharides Coating on Antibacterial Potential and Drug Loading and Releasing Capability of Plasma Treated Polylactic Acid Films" International Journal of Molecular Sciences 23, no. 15: 8821. https://doi.org/10.3390/ijms23158821
APA StyleKarakurt, I., Ozaltin, K., Pištěková, H., Vesela, D., Michael-Lindhard, J., Humpolícek, P., Mozetič, M., & Lehocky, M. (2022). Effect of Saccharides Coating on Antibacterial Potential and Drug Loading and Releasing Capability of Plasma Treated Polylactic Acid Films. International Journal of Molecular Sciences, 23(15), 8821. https://doi.org/10.3390/ijms23158821

